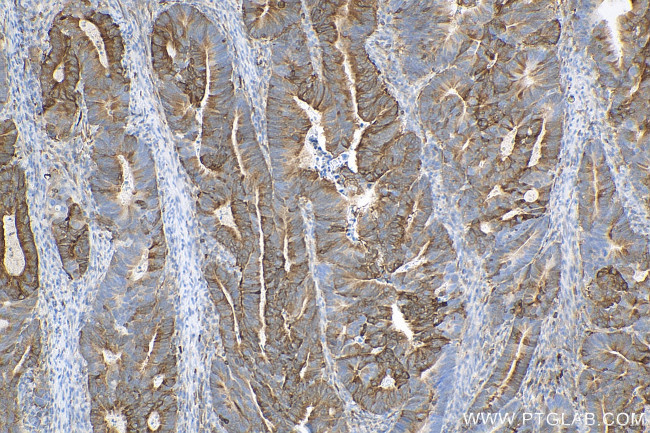
PHGDH Antibody in Immunohistochemistry (Paraffin) (IHC (P))

Search
Proteintech
PHGDH Recombinant Rabbit Monoclonal Antibody (5L16)
{{$productOrderCtrl.translations['antibody.pdp.commerceCard.promotion.promotions']}}
{{$productOrderCtrl.translations['antibody.pdp.commerceCard.promotion.viewpromo']}}
{{$productOrderCtrl.translations['antibody.pdp.commerceCard.promotion.promocode']}}: {{promo.promoCode}} {{promo.promoTitle}} {{promo.promoDescription}}. {{$productOrderCtrl.translations['antibody.pdp.commerceCard.promotion.learnmore']}}
产品信息
81986-1-RR
种属反应
宿主/亚型
Expression System
分类
类型
克隆号
抗原
偶联物
形式
纯化类型
保存液
内含物
保存条件
运输条件
产品详细信息
Immunogen sequence: SFGVQQLPLE EIWPLCDFIT VHTPLLPSTT GLLNDNTFAQ CKKGVRVVNC ARGGIVDEGA LLRALQSGQC AGAALDVFTE EPPRDRALVD HENVISCPHL GASTKEAQSR CGEEIAVQFV DMVKGKSLTG VVNAQALTSA FSPHTKPWIG LAEALGTLMR AWAGSPKGTI QVITQGTSLK NAGNCLSPAV IVGLLKEASK QADVNLVNAK LLVKEAGLNV TTSHSPAAPG EQGFGECLLA VALAGAPYQA VGLVQGTTPV LQGLNGAVFR PEVPLRRDLP LLLFRTQTSD PAMLPTMIGL LAEAGVRLLS YQTSLVSDGE TWHVMGISSL LPSLEAWKQH VTEAFQFHF
靶标信息
PHGDH gene encodes the enzyme which is involved in the early steps of L-serine synthesis in animal cells. L-serine is required for D-serine and other amino acid synthesis. The enzyme requires NAD/NADH as a cofactor and forms homotetramers for activity. Mutations in this gene have been found in a family with congenital microcephaly, psychomotor retardation and other symptoms. Multiple alternatively spliced transcript variants have been found, however the full-length nature of most are not known.
仅用于科研。不用于诊断过程。未经明确授权不得转售。
篇参考文献 (0)
生物信息学
蛋白别名: 2-oxoglutarate reductase; 3-PGDH; 3-phosphoglycerate dehydrogenase; 3-phosphoglycerate dehyrogenase; A10; D-3-phosphoglycerate dehydrogenase; epididymis secretory protein Li 113; Malate dehydrogenase
基因别名: 3-PGDH; 3PGDH; 4930479N23; A10; HEL-S-113; NLS; NLS1; PDG; PGAD; PGD; PGDH; PGDH3; PHGDH; PHGDHD; SERA
UniProt ID: (Human) O43175, (Mouse) Q61753, (Rat) O08651
Entrez Gene ID: (Human) 26227, (Mouse) 236539, (Rat) 58835